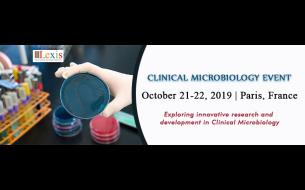

Education
 December01Holiday Inn Birmingham City Centre, Birmingham
December01Holiday Inn Birmingham City Centre, BirminghamYoung Teachers Consultation Conference
October21Coming Soon, Paris
October21Coming Soon, ParisClinical Microbiology Event
Lexis Conferences feels immense pleasure to organize Clinical Microbiology event with the theme ”Exploring innovative...
 November02
November02 April09One America Square , London
April09One America Square , LondonThe Engaging Digital Comms Conference...
Book Before 15th November & Save Between £125 & £300 | Limited Places Available Book before 1st November and save...
 February27One Great George Street, Westminster, London
February27One Great George Street, Westminster, LondonThe Operational Excellence Conference
To see the full day agenda, download our brochure: https://opexcultureconference.com/programme Air Jordan VII 7 Retro...
 November01
November01 October30
October30 November01
November01 October31
October31
